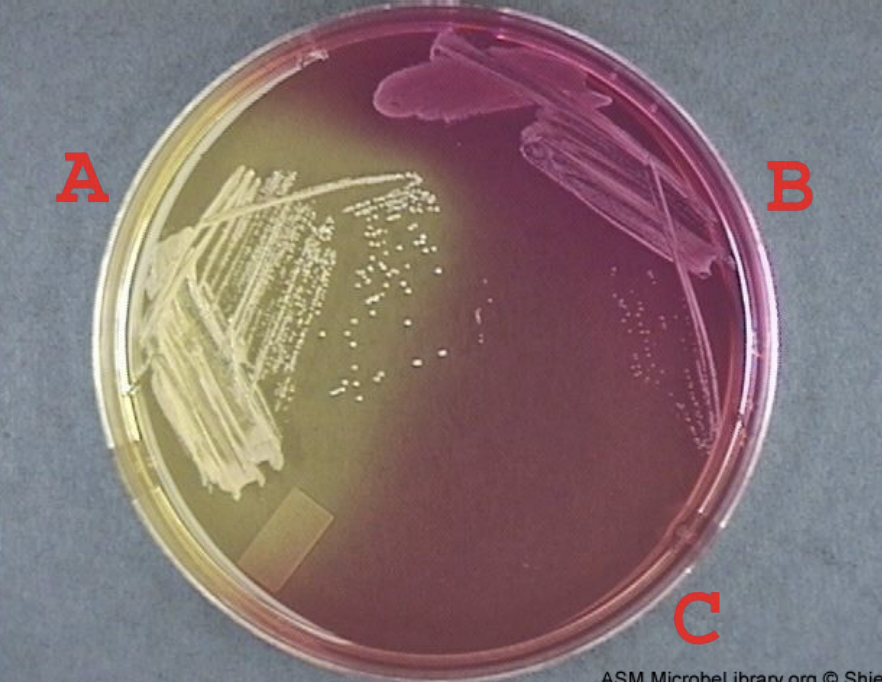
<p>Classification: Differential and Selective</p><p>Ingredients: Beef extract, Peptone</p><p>Lab Usage: Isolates staphylococci aureus</p><p>Results: Yellow - mannitol fermenting, pink - nonfermenting colony</p>
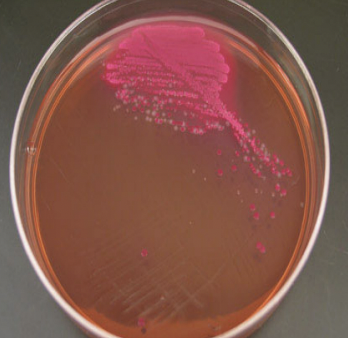
<p>Classification: Differential</p><p>Ingredients: Crystal violet, Salt, Lactose, pH indicator</p><p>Lab Usage: Differs gram negative and gram positive bacteria</p><p>Results: red/pink - ferments lactose</p>

1/42
Name | Mastery | Learn | Test | Matching | Spaced |
|---|
No study sessions yet.
Starch Agar
Classification: Differential medium
Ingredients: Starch, Beef Extract
Lab Usage: Detects microogranisms that break down starch
Carbohydrate Broth
Classification: Differential
Types: Dextrose, Lactose, Sucrose, Maltose
Lab Usage: Determines if the bacteria can use carbohydrates, turns carbohydrates into organic acids with or without broths
Result: red - negative, yellow - postive
Mannitol Agar
Classification: Differential and Selective
Ingredients: Beef extract, Peptone
Lab Usage: Isolates staphylococci aureus
Results: Yellow - mannitol fermenting, pink - nonfermenting colony
Eosin Methylene Blue Agar
Classification: Differential Medium and Selective
Ingredients: Lactose, Peptone, Methylene blue, Phosphate
Lab Usage: Used for gram negative bacteria against gram positive bacteria
MacConkey Agar
Classification: Differential
Ingredients: Crystal violet, Salt, Lactose, pH indicator
Lab Usage: Differs gram negative and gram positive bacteria
Results: red/pink - ferments lactose
Catalase Test
Classification: Differential
Ingredients: Hydrogen peroxide
Lab Usage: Determines staphylococci or streptococci
Oxidase Test
Classification: Differential
Ingredients: Tetra-methyl, Zinc, Magnesium
Lab Usage: Determines if organism can oxidase an enzyme
Results: if color does not change then the bacteria is negative

Coagulase Test
Classification: Differential
Ingredients: Saline
Lab Usage: Shows the difference between staphylococcus from gram negative and catalase positive
Maltose Broth
Classification: Differential
Ingredients: Peptone, Beef extract, Sodium chloride
Lab Usage: can catalyze enzymes, hydrolysis of starch
Triple Sugar Iron Agar (TSI)
Classification: Differential
Ingredients:Glucose, Sucrose, Lactose, Iron
Lab Usage: Used in lab due to its ability to ferment sugars
Results: cloudy butt indicates fermentation, production of gas will show bubbles

Citrate Agar
Classification: Differential
Ingredients: Sodium citrate, Sodium chloride, Bromothymol blue
Lab Usage: Tests for citrase
Blue - positive
Green - negative
Skim Milk Agar
Classification: Differential
Ingredients: Yeast extract, Skim milk powder, Glucose
Lab Usage: Tests for casease
Clear zone around bacteria - positive
No clear zone to be found - negative
Sulfur, Indole production, motility Agar(SIM)
Classification: Differential
Ingredients: Peptone, Iron, Sodium
Lab Usage: Indicates sulfur, indole, motility
Positive sulfur - black precipitable
Positive Indole - pink band on top after applying Kovac’s reagent
Positive motility - cloudy butt
Nutrition Gelatin
Classification: Differential
Ingredients: Animal bones, cartilage
Lab Usage: Tests for gelatinase
Turns to liquid - positive
Stays solid - negative
Urea Broth
Classification: Differential medium
Ingredients: Yeast extract, potassium phosphate, urea, phenol red
Lab Usage: Formulates test for fast urease postive organisms
Results: liquid red if positive

Blood Agar
Classification: Differential
Ingredients: 5% sheep blood cells
Lab Usage: tests the ability of organisms to produce hemolysins
CAMP Test
Classification: biochemical test
Function: tests for streptococcus agalactiae
Lab Usage: identifies bacterial organisms from patient specimens
Nitrate Broth
Classification: Differential
Ingredients: Nutrients, potassium nitrate
Lab Usage: Determines if organisms can reduce nitrate
MRVP
Classification: Interpretation
Ingredients: peptone buffers, dextrose
Lab Usage: determines which fertilization is used to utilize glucose
Results: MR - test turns red (then positive), VP - turns pink/red (then positive)
Dextrose Broth
Classification: Liquid medium
Ingredients: Dextrose, peptone
Lab Usage: determines is microbe can use glucose for carbon or energy source
Sucrose Broth
Classification: Differential
Ingredients: Sucrose. sodium chloride, peptone
Lab Usage: Used to study sucrose
Lactose Broth
Classification: Liquid medium
Ingredients: Lactose, sodium chloride, peptone
Lab Usage: Used for isolation of salmonella
Nutrient Agar
Classification: Simple media
Ingredients: Peptone, beef extract
Lab Usage: Used to test many bacterium
Colony Morphologies (8)
elevation (raised, flat)
margin (entire, filamentous)
size (diameter)
shape (circular, irregular, rhizoid)
opacity (opaque, transparent)
color (red, white, yellow, tan)
consistency (soft, hard)
surface (tough, dull, shiny, glistening)
Endospore Stain
smear
bibulous paper
boil water
place malachite green (5 min, primary stain)
rinse
safranin (2 min, control stain)
rinse
blot dry
results (Green - endospores, Pink - cells)
Acid Fast Stain
smear
bibulous paper
carbol fuchsin (6 min, primary stain)
bunsen burner with stain on slide
acid alcohol (30 sec, decolorzier)
rinse
methylene blue (1 min, counter stain)
rinse
blot
results (positive - pink cells, negative - blue cells)
Capsule Stain
india ink dot
mix in bacteria
spread across with slide
air dry
crystal violet (5 min)
shake it off
air dry
heat fix
results (white - capsule, crystal violet - cell)
Negative Stain
india ink dot
mix bacteria
spread across with slide
air dry
heat fix
results (clear - bacteria, background - stain)
Gram Stain
smear
crystal violet (1 min, primary stain)
rinse
iodine (1 min, moderant)
rinse
acid alcohol (5, sec, decolorizer)
rinse
safranin (1 min, secondary stain)
rinse
blot
results ( pink/red - gram negative, purple - gram positive)
Simple Stain
smear
air dry
heat fix
immersion oil
look under microscope
Pattern: Single Cocci
one circle
Pattern: Single Bacilli
one rod
Pattern: Diplo Cocci
two circles next to eachother
Pattern: Diplo Bacilli
two rods next to eachother
Pattern: Tetrad Cocci
Four circles in a quadrant
Pattern: Tetrad Bacilli
Four rods in a quadrant
Pattern: Strepto Cocci
a bunch of circles formed in a chain
Pattern: Stepto Baccili
a bunch of rods formed in a chain
Pattern: Staphylo Cocci
a bunch of circles random shaped and bunched together
Pattern: Staphylo Baccili
a bunch of rods random shaped and bunched together
Gram - VS Gram +
Gram - = pink/red
Gram + = purple
Label on agar should be faced
bottoms up
Simmons Citrate Agar
Classification: medium
Ingredients: citrate
Lab Usage: citrate is used as a carbon and nitrogen source
Results: test tube will turn blue if positive
